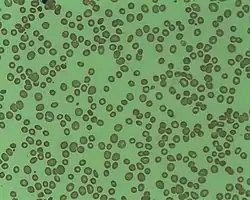

تفاوت حجم الكريات الحمراء
"تفاوت حجم كريات الدم الحمراء" (بالإنجليزية: Anisocytosis) هو مصطلح طبي يعني أن خلايا الدم الحمراء للمريض غير متساوية الحجم، وهذا أمر شائع في فقر الدم وغيره من حالات أمراض الدم. قد ينخدع التشخيص إذا ارتفع عدد كريات الدم البيضاء (WBC count)، أو التصقت كريات الدم الحمراء ببعضها، أو تكسرت كريات الدم الحمراء إلى شظايا متعددة، أو حدث اضطراب "تعملق الصفائح الدموية" (بالإنجليزية: Giant platelet disorder) أو تكتلت الصفائح الدموية مع بعضها. وبالإضافة إلى ذلك، فإن "تفاوت حجم كريات الدم الحمراء" سمة من سمات دم الأبقار.
| تفاوت حجم الكريات الحمراء Anisocytosis | |
|---|---|
![]() ![]() شريحتان مختلفتان تبينان كريات دم حمراء بشرية لمرضي "تفاوت أحجام الكريات الحمراء". | |
إن توزيع مدى تباين (بالإنجليزية: distribution width) كريات الدم الحمراء (RDW) هو مقياس مُعبِّر عن "تفاوت حجم كريات الدم الحمراء"، [1] ويتم حسابه على أنه ناتج القسمة بين معامل تباين توزيع أحجام كريات الدم الحمراء مقسومًا على حجم الكرية المتوسط (MCV)، معبرًا عنه كنسبة مئوية.
الأنواع
يُعَرَّف "تفاوت حجم كريات الدم الحمراء" بحسب توزيع مدى تباين كريات الدم الحمراء (RDW)، ويُصَنًّف بحسب حجم كريات الدم الحمراء مُقاساً بحجم الكرية المتوسط (MCV). وفقا لهذا، فإنه يمكن تقسيمها كالتالي:
- "تفاوت حجم كريات الدم الحمراء" مع "صغر الكريات الحمر" (بالإنجليزية: microcytosis) – نقص الحديد، فقر الدم المنجلي.
- "تفاوت حجم كريات الدم الحمراء" مع "كبر الكريات الحمر" (بالإنجليزية: macrocytosis) – نقص حمض الفوليك أو نقص فيتامين ب12، أو فقر الدم الانحلالي بالمناعة الذاتية، أو علاج كيميائي سام للخلايا، أو مرض الكبد المزمن، أو متلازمة خلل التنسج النقوي (النخاعي).
- يزداد "توزيع مدى تباين كريات الدم الحمراء" (RDW) مع نقص الحديد وفقر الدم، وتكون منخفضة أو عادية في الثلاسيميا الكبرى، والثلاسيميا المتوسطة.
- "تفاوت حجم كريات الدم الحمراء" مع أحجام طبيعية لكريات الدم الحمراء – بدايات نقص حديد أو بدايات نقص فيتامين ب12 أو بدايات نقص حمض الفوليك، أو فقر الدم الثنائي الشكل، أو فقر الدم المنجلي، أومرض الكبد المزمن، أو متلازمة خلل التنسج النقوي (النخاعي). [2]
الإشتقاق اللغوي
الاسم الأجنبي "Anisocytosis" مشتق من اليونانية القديمة عن طريق لصق عدة لواحق كالتالي:
- an- بدون، أو سلبي الجودة
- iso- على قدم المساواة
- cyt- الخلية
- osis حالة [3]
أي: "حالة عدم المساواة بين الخلايا".
المراجع
- باربرا جين بين (2006). Blood cells: a practical guide. Wiley-Blackwell. صفحات 66–. ISBN 978-1-4051-4265-6. مؤرشف من الأصل في 3 يناير 2020. اطلع عليه بتاريخ 10 نوفمبر 2010. الوسيط
|CitationClass=تم تجاهله (مساعدة) - Red Cell Distribution Width (RDW) في موقع إي ميديسين
- (PDF) https://web.archive.org/web/20180820193730/http://cal.vet.upenn.edu/projects/histo/Etymology.pdf. مؤرشف من الأصل (PDF) في 20 أغسطس 2018. الوسيط
|CitationClass=تم تجاهله (مساعدة); مفقود أو فارغ|title=(مساعدة)
- بوابة طب